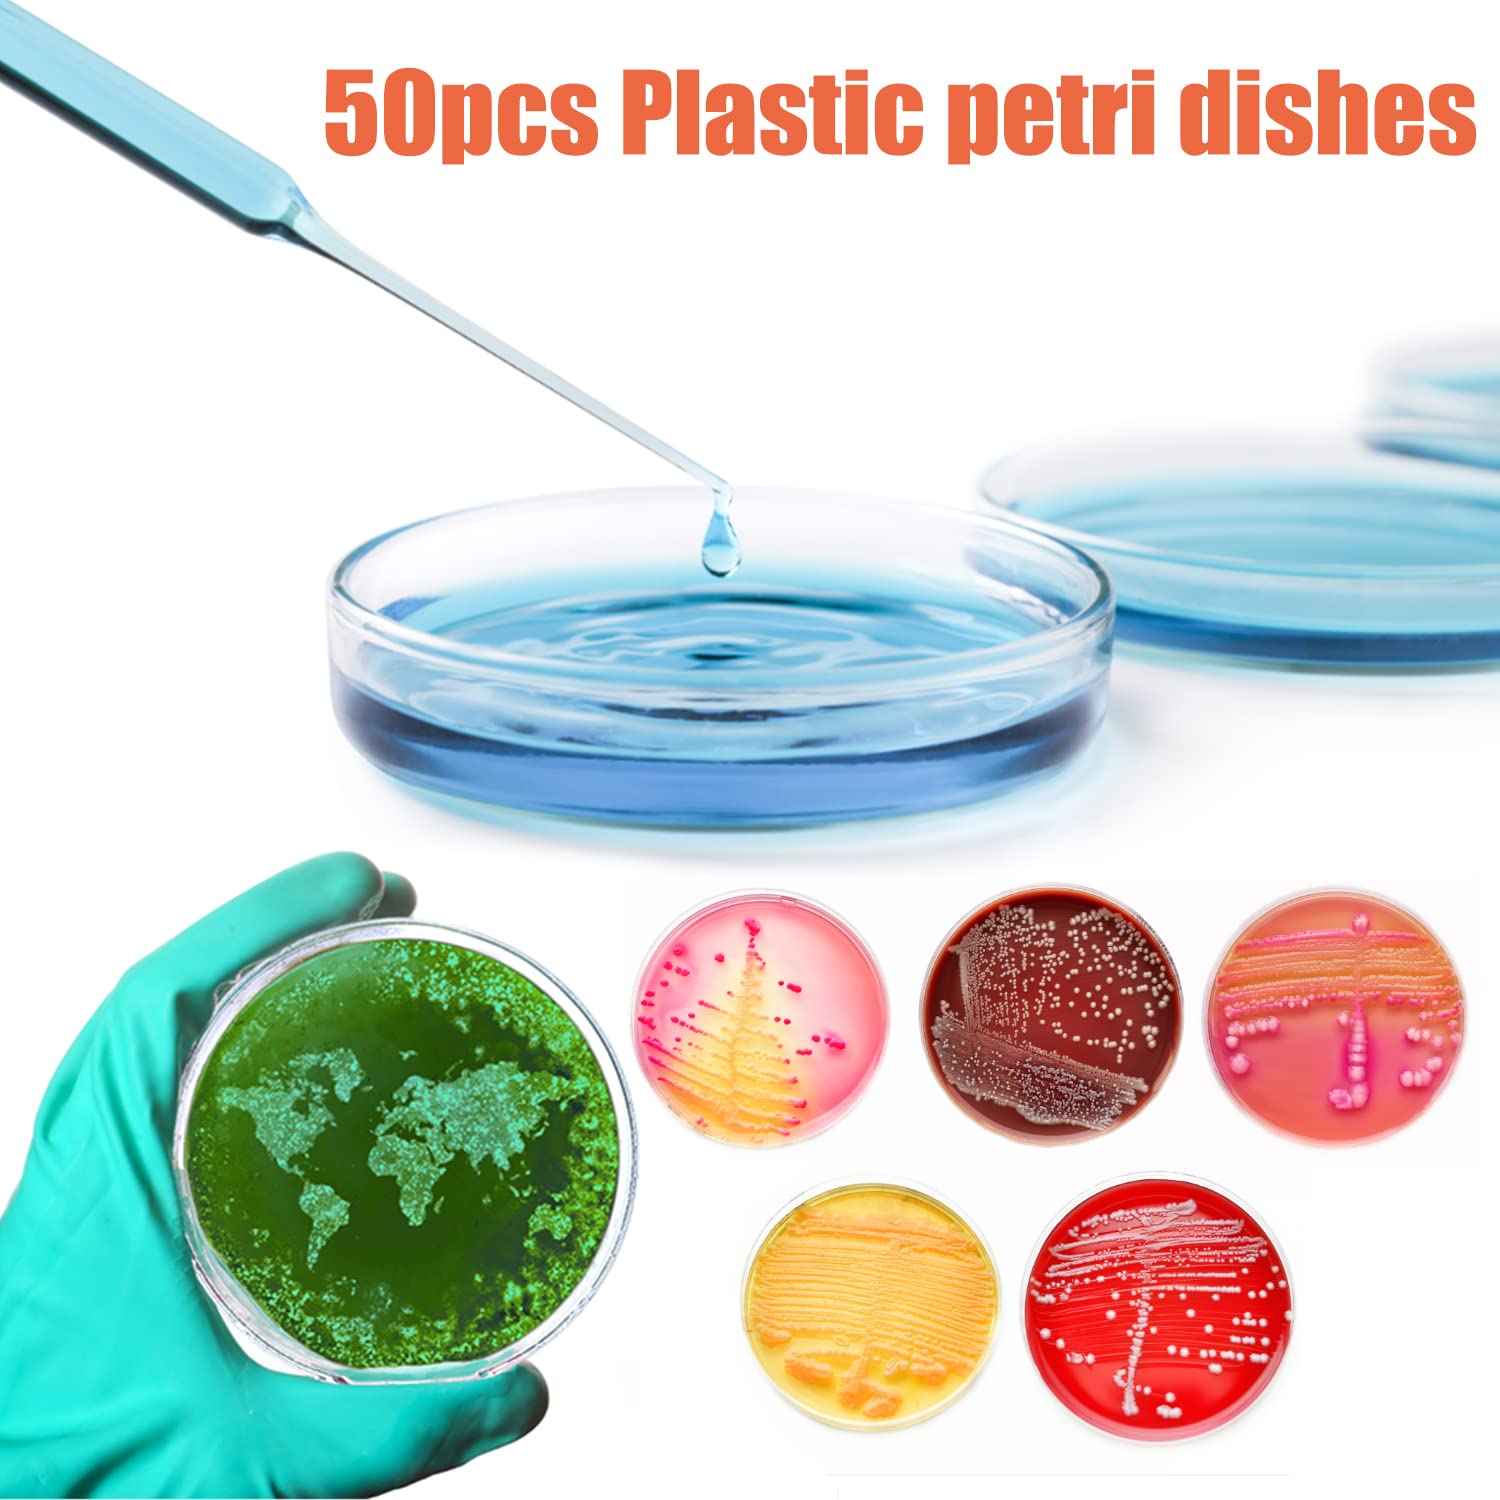
https://m.media-amazon.com/images/I/71Yww-byLyL._SL1500_.jpg
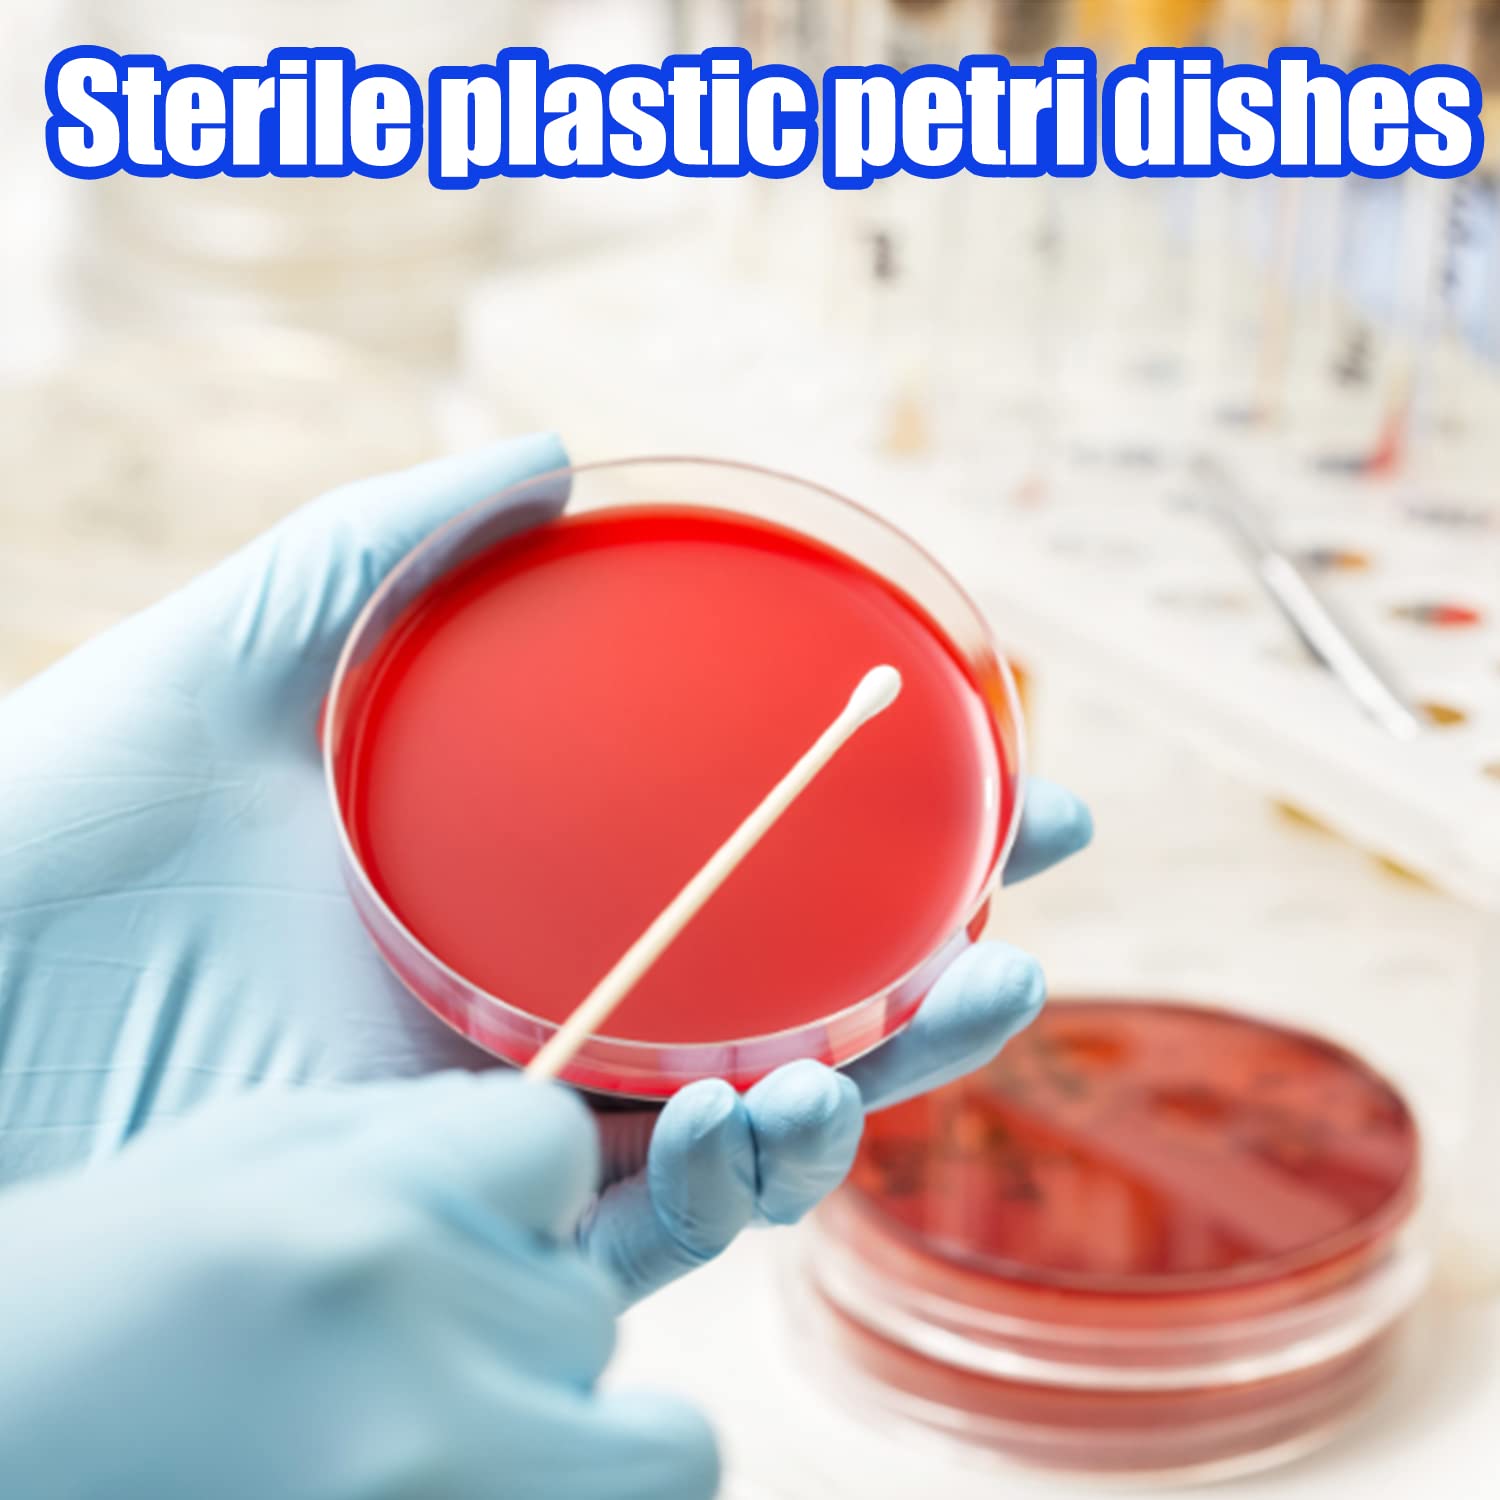
https://m.media-amazon.com/images/I/618PFYSkO2L._SL1500_.jpg

Auction Ended
50 Pack Plastic Petri Dishes with Lids,90 x 15mm Sterile Plastic Petri Dishes,Bioresearch Sterile Petri Dishes for Medical,Biological,School Science Projects 50pcs 90MM
Sold
Good Condition
QTY 1
$3.41
MSRP
MSRP is a sample online retail price.
$17.00
Last Update:
12/18/2025, 12:24 AM ESTItem Information
MSRP:
MSRP is a sample online retail price.
$17.00
Brand:
Qiuttnqn
Condition:
Good Condition
Description:
N/A
Lot Code:
ORG6675718
Width:
Depth:
Weight:
Length:
Additional Info:
Good Condition
Pickup Location:
8485 Broadwell Road, Cincinnati OH 45244
Auction Number
BRO2402934